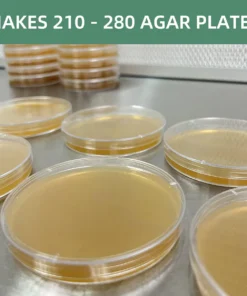

Myco Labs Leichter Malzextrakt (LME) Agar-Pulvermischung – Ergibt über 200 Agarplatten 200 g (7 oz)
€19.99
Bringen Sie Ihre Mykologie-Projekte auf das nächste Level – mit dem Myco Labs Malzextrakt-Agar Pulver Blend. Diese speziell formulierte, vorgemischte Nährlösung wurde entwickelt, um kräftiges, gesundes Myzel zuverlässig zu kultivieren und optimale Wachstumsbedingungen zu schaffen.
Myco Labs Leichter Malzextrakt (LME) Agar-Pulvermischung – Ergibt über 200 Agarplatten 200 g (7 oz)
Myco Labs Leichter Malzextrakt (LME) Agar-Pulvermischung – Ergibt über 200 Agarplatten 200 g (7 oz) bringen Sie Ihre Mykologie-Projekte auf ein professionelles Niveau mit dem Myco Labs (LME) Hellen Malzextrakt-Agar Pulver – 200g. Diese hochwertige, vorgemischte Hausrezeptur wurde speziell für die Kultivierung von robustem und vitalem Myzel entwickelt.
Die 200g-Mischung (ca. 7oz) kombiniert:
-
Extra helles Malzextrakt
-
Hochfestes Agar-Agar-Pulver
-
Sojapepton
Alle Komponenten werden in optimal abgestimmten Labor-Verhältnissen gemischt, um eine konstante und reproduzierbare Nährstoffbasis für verschiedenste Myzelstämme zu gewährleisten.
Mit nur einer Packung lassen sich über 200 Malzextrakt-Agar-Platten (LME) herstellen – eine wirtschaftliche Lösung für Hobbyzüchter, Bildungseinrichtungen und professionelle Labore.
Produktvorteile im Überblick
Hochwertige Laborzutaten
Extra helles Malzextrakt, starkes Agar-Agar und Sojapepton – präzise gemischt nach professionellen Standards.
Wissenschaftlich abgestimmte Rezeptur
Optimale Nährstoffverhältnisse für vielfältige Myzelkulturen.
Hohe Ausbeute
Über 200 LME-Agarplatten pro 200g-Beutel.
Zeitersparnis
Vorgemischt – einfach Wasser hinzufügen und sterilisieren.
Vielseitige Anwendung
Ideal für:
-
Isolierung von Kulturen
-
Klonen von Pilzen
-
Stammselektion
-
Labor- und Forschungszwecke
Konstante Ergebnisse
Entwickelt für zuverlässige, wiederholbare Performance bei jeder Charge.
Anwendung – So verwenden Sie das Myco Labs LME Agar Pulver
-
Abmessen:
16g Pulver pro 500ml destilliertes Wasser für Standard-Agarplatten verwenden.
(Verhältnis je nach Bedarf anpassbar.) -
Auflösen:
Pulver gründlich im Wasser verrühren, bis es vollständig gelöst ist. -
Sterilisieren:
Lösung in ein autoklavierbares Gefäß (z. B. Glas oder Pyrex) füllen und bei 15 PSI für 20 Minuten im Schnellkochtopf oder Autoklaven sterilisieren. -
Abkühlen & Ausgießen:
Auf ca. 50–60 °C abkühlen lassen und unter sterilen Bedingungen (z. B. Laminar-Flow-Haube) in Petrischalen gießen. -
Aushärten & Beimpfen:
Agar vollständig erstarren lassen, anschließend inokulieren.
Lagerung & Haltbarkeit
-
Ungeöffnet trocken und kühl lagern
-
Nach Öffnung innerhalb von 6 Monaten verbrauchen
-
Pulver stets luftdicht verschlossen aufbewahren
Ideal geeignet für
-
Mykologische Labore
-
Professionelle Pilzzuchtbetriebe
-
Hobby-Mykologen
-
Bildungseinrichtungen
-
Forschung & Stammselektion
Be the first to review “Myco Labs Leichter Malzextrakt (LME) Agar-Pulvermischung – Ergibt über 200 Agarplatten 200 g (7 oz)” Cancel reply
Related products
Agar Werkzeuge & Zubehör
Magnetrührplatte mit Rührstäben – 4000 U/min Laborrührplatte
Agar Werkzeuge & Zubehör
Agar Werkzeuge & Zubehör
Sterilisierte Malzextrakt-Agar-Schrägagar-Röhrchen (5er-Packung)

Reviews
There are no reviews yet.